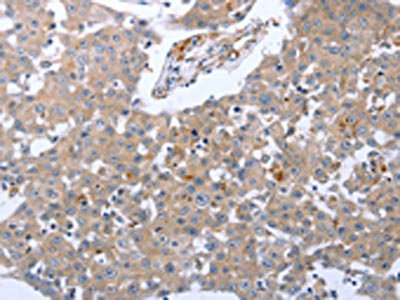

RASSF1 Antibody
-
中文名稱:RASSF1兔多克隆抗體
-
貨號:CSB-PA729792
-
規格:¥1100
-
圖片:
-
The image on the left is immunohistochemistry of paraffin-embedded Human breast cancer tissue using CSB-PA729792(RASSF1 Antibody) at dilution 1/30, on the right is treated with synthetic peptide. (Original magnification: ×200)
-
The image on the left is immunohistochemistry of paraffin-embedded Human colon cancer tissue using CSB-PA729792(RASSF1 Antibody) at dilution 1/30, on the right is treated with synthetic peptide. (Original magnification: ×200)
-
Gel: 10%SDS-PAGE, Lysate: 40 μg, Lane: Mouse brain tissue, Primary antibody: CSB-PA729792(RASSF1 Antibody) at dilution 1/550, Secondary antibody: Goat anti rabbit IgG at 1/8000 dilution, Exposure time: 2 minutes
-
-
其他:
產品詳情
-
Uniprot No.:
-
基因名:
-
別名:123F2 antibody; Cardiac specific ras association domain family 1 protein antibody; cardiac-specific ras association domain family 1 protein; 123F2 antibody; NORE2A antibody; OTTHUMP00000195503 antibody; OTTHUMP00000195504 antibody; OTTHUMP00000195505 antibody; OTTHUMP00000195507 antibody; Pancreas specific ras association domain family 1 protein antibody; Ras association (RalGDS/AF 6) domain family member 1 antibody; Ras association domain-containing protein 1 antibody; RASF1_HUMAN antibody; Rassf1 antibody; RASSF1A antibody; RDA32 antibody; REH3P21 antibody; Tumor suppressor protein RDA32 antibody; WUGSC:H_LUCA12.5 antibody
-
宿主:Rabbit
-
反應種屬:Human,Mouse
-
免疫原:Synthetic peptide of Human RASSF1
-
免疫原種屬:Homo sapiens (Human)
-
標記方式:Non-conjugated
-
抗體亞型:IgG
-
純化方式:Antigen affinity purification
-
濃度:It differs from different batches. Please contact us to confirm it.
-
保存緩沖液:-20°C, pH7.4 PBS, 0.05% NaN3, 40% Glycerol
-
產品提供形式:Liquid
-
應用范圍:ELISA,WB,IHC
-
推薦稀釋比:
Application Recommended Dilution ELISA 1:1000-1:5000 WB 1:200-1:1000 IHC 1:25-1:100 -
Protocols:
-
儲存條件:Upon receipt, store at -20°C or -80°C. Avoid repeated freeze.
-
貨期:Basically, we can dispatch the products out in 1-3 working days after receiving your orders. Delivery time maybe differs from different purchasing way or location, please kindly consult your local distributors for specific delivery time.
-
用途:For Research Use Only. Not for use in diagnostic or therapeutic procedures.
相關產品
靶點詳情
-
功能:Potential tumor suppressor. Required for death receptor-dependent apoptosis. Mediates activation of STK3/MST2 and STK4/MST1 during Fas-induced apoptosis by preventing their dephosphorylation. When associated with MOAP1, promotes BAX conformational change and translocation to mitochondrial membranes in response to TNF and TNFSF10 stimulation. Isoform A interacts with CDC20, an activator of the anaphase-promoting complex, APC, resulting in the inhibition of APC activity and mitotic progression. Inhibits proliferation by negatively regulating cell cycle progression at the level of G1/S-phase transition by regulating accumulation of cyclin D1 protein. Isoform C has been shown not to perform these roles, no function has been identified for this isoform. Isoform A disrupts interactions among MDM2, DAXX and USP7, thus contributing to the efficient activation of TP53 by promoting MDM2 self-ubiquitination in cell-cycle checkpoint control in response to DNA damage.
-
基因功能參考文獻:
- Tissues from patients with serous and non-serous EOC showed significantly higher promoter methylation of EGFL7 and RASSF1 compared to benign cases. PMID: 29778234
- Transcriptome assay unclosed that RASSF1A promoted IL-6 expression in A375 cells, which in turn activate JAK2/STAT3 signaling. PMID: 30074127
- Rassf1a rs2236947 is a promising biomarker for patients treated with cetuximab plus chemotherapy. PMID: 27698403
- Low RASSF1A expression is associated with gastric cancer. PMID: 30106448
- methylation of BRCA1, RASSF1A and GSTP1 was found in 58.23 %, 74.68 % and 59.49 % of tumor tissues and 51.90 %, 63.29 % and 35.44 % of corresponding adjacent tissues, respectively PMID: 30049201
- Our study established that RASSF1A hypermethylation might have a potential value in the clinical diagnosis of colorectal cancer PMID: 30082160
- Effect of decitabine pretreatment on sensitivity of bladder cancer cells towards chemotherapeutic drugs was also studied. Decitabine treatment leads to restoration of RASSF1A, activation of hippo pathway followed by decreased expression of its oncogenic downstream targets (CTGF & CYR61). PMID: 29368096
- the use of RASSF1A promoter methylation could distinguish ovarian cancer and low malignant potential tumors. -RASSF1A promoter methylation may not be correlated with the clinical features and the survival of ovarian cancer patients. PMID: 29130987
- the methylation positive rates of SHOX2 with RASSF1A in stage III were both higher than the other stages of lung cancer PMID: 28325362
- Tested if RASSF1A polymorphisms associated with ovarian cancer and with tumor grade and stage. Five tagging single nucleotide polymorphisms (SNPs) (rs4688728G>T, rs72932987C>T, rs1989839C>T, rs2073497A>C, and rs2236947A>C) were evaluated. The CT genotype of rs1989839 was associated with the patients with ovarian cancer (P=0.001), and was significantly correlated with tumor grade and stage (P=0.008). PMID: 29670073
- No significant differences were presented in DNA methylation levels of RASSF1A and ATM between the sporadic breast cancer cases and the healthy controls. PMID: 29562656
- High Promoter Methylation of RASSF1A gene is associated with Breast Cancer. PMID: 29480000
- Hypermethylation of RASSF1 gene is associated with neuroendocrine tumors. PMID: 29851970
- The present work proved that there was a higher frequency of RASSF1A methylation and a decrease in its serum level in patients with ovarian cancer compared to controls as well as in the high-grade tumor patients compared to low grade ones and also in advanced ovarian tumor stage compared to early stages. PMID: 29098560
- Promoter methylation of RASSF1A can influence sensitivity to oxaliplatin-based chemotherapy, which can be used to predict outcomes for patients with stage II and III Colorectal Cancer PMID: 29128865
- The meta-analysis indicates a role of the RASSF1A promoter hypermethylation from peripheral blood in testicular germ cell tumors. PMID: 28871003
- RASSF1A is a tumour suppressor gene epigenetically dysregulated in NET. Aberrant methylation of RASSF1A has been reported in various tumours, but this is the first report of RASSF1A hypermethylation in TETs. PMID: 28838380
- Study shows that recombinant human bone morphogenetic protein-2 activates hippo signaling through RASSF1 in esophageal cancer cells PMID: 27230238
- There were significant associations between RASSF1A promoter hypermethylation and Oral Cancer risk.RASSF1A promoter hypermethylation exerted higher frequency in the Tongue Tumor than other site tumor in mouth. PMID: 29538221
- RASSF1A is expressed in differentiating stem cells. PMID: 29382819
- Hypermethylation of RASSF1A gene is associated with Colon Cancer. PMID: 26671036
- Data show that silencing DNA methyltransferase 1 (DNMT1) increased expression of tumor suppressor genes, RASSF1A and DAPK, in esophageal squamous cell carcinoma (ESCC) cells and ESCC xenograft in nude mice. PMID: 27286455
- Describe a novel interaction between Rheb and the tumor suppressor RASSF1A. This interaction may allow coordinate upregulation of Hippo while TOR is suppressed to modulate the balance of apoptosis and autophagy in lung tumor cells. PMID: 27034171
- Gestational age-dependent increase of hypermethylated RASSF1A; the fetal specific epigenetic marker in maternal plasma was demonstrated, in an Indian study group of normal pregnant women. PMID: 27165812
- the RASSF1 gene polymorphism influences molecular carcinogenesis and clinic pathological features of hepatocellular carcinoma within the Egyptian population PMID: 26921475
- We report for the first time that RASSF1A promoter methylation provides significant prognostic information in high-grade serous ovarian cancer patients. PMID: 28206954
- The main finding of this study was the significant association between RASSF1A promoter methylation and increased EC risk. PMID: 28669560
- Data suggest that the overexpression of DNMT3B4 may play an important role in human kidney tumorigenesis through chromosomal instability and methylation of RASSF1A. PMID: 28160561
- Methylation status of the RASSF1A gene promoter was strongly related to melanoma susceptibility but no significant difference was found between RASSF1A gene promoter methylation and the prognosis and clinical-pathological features of melanoma. PMID: 28207831
- Our results suggest a multifactorial role of RASSF1A in suppression of liver carcinogenesis PMID: 26980762
- rs1989839C/T is an important predictor of osteosarcoma risk and outcome. The CT genotype of rs1989839 is highly related to elevated risk of osteosarcoma. Furthermore, rs1989839C/T is also associated with the Enneking stage of osteosarcoma and risk of lung metastasis. One of the other 4 SNPs, rs2236947A/C, shows a borderline significance in predicting osteosarcoma risk. PMID: 27880743
- For the first time, we performed analysis of DNA methylation in SMARCB1/INI1-deficient sinonasal carcinomas, reporting on significantly higher methylation of RASSF1 gene in this neoplasm. PMID: 28069272
- High methylation in the RASSF1A promoter region is associated with lung cancer. PMID: 27716889
- GSTP1, APC and RASSF1 gene methylation in prostate cancer samples: comparative analysis of MS-HRM method and Infinium HumanMethylation450 BeadChip beadchiparray diagnostic value PMID: 28026816
- Compared with adjacent normal tissues, the methylation frequencies of WIF-1, RASSF1A, and CDH13 genes were significantly higher but the mRNA levels of these 3 genes were significantly lower in EC tissues. The survival rates of patients with WIF-1, RASSF1A, and CDH13 methylations were significantly lower than those of patients without methylation PMID: 27506957
- The presence of higher RASSF1A methylation levels in fine-needle aspiration cytology specimens of nodular goitre may be useful in the assessment of oncological risk. PMID: 26457492
- this meta-analysis demonstrated that RASSF1A promoter methylation is significantly associated with increased risk of renal cell cancer PMID: 27173228
- Overexpression of RASSF1A downregulated the cyclin D1. PMID: 26750098
- Results show that RASSF1A is involved in colorectal tumorigenesis. Its promotor region is bind to miR-181b stimulating its expression. PMID: 26935905
- The meta-analysis suggested that there was a significant association between aberrant RASSF1A methylation and head and neck squamous cell carcinoma. PMID: 26857374
- The present meta.analysis provides convincing evidence that the promoter methylation ratio of RASSF1A and p16 is associated with clinicopathological features in lung cancers, and could be used as effective biomarkers in early diagnosis in lung cancers. PMID: 27072261
- Loss of RASSF1A is associated with gastric cancer. PMID: 26735582
- Different genetic mechanisms seem to contribute to RASSF1 deregulation in this setting, but RASSF1 methylation does not seem to substantially affect RASSF1 isoforms expression. PMID: 26754001
- RASSF1C gene is not involved in Clear-cell renal cell carcinoma (ccRCC)progression and we propose that the measurements of RASSF1A mRNA levels in paired tumor-normal kidney tissue could serve as a new prognostic factor in ccRCC PMID: 26648328
- Results indicate that hypermethylation of tumor suppressor protein RASSF1A and docking protein 1 (DOK1) contributes to hepatocarcinogenesis and is associated to clinicopathological characteristics. PMID: 27078152
- Data indicate tumor suppressors TP73, RASSF1A, MLH1 and BRCA1 as possible biomarkers to distinguish Pleomorphic invasive lobular cancer (pleomorphic ILC} from classic ILC and infiltrative ductal cancer (IDC). PMID: 26392358
- Interaction between HPV infection and RASSF1A promoter methylation is associated with the development of cervical cancers. PMID: 26320446
- Hypermethylation of RASSF1A gene promoter is associated with esophageal squamous cell carcinoma. PMID: 25886188
- RASSF1A promotes the translocation of cytosolic PRMT5 to microtubules.PRMT5 co-localizes with RASSF1A on stabilized microtubules. PMID: 26482848
- Tumor-adjacent tissues showed higher methylation status of RASSF1A, HIN-1 and MGMT promoters. PMID: 26370119
顯示更多
收起更多
-
亞細胞定位:[Isoform A]: Cytoplasm, cytoskeleton. Cytoplasm, cytoskeleton, microtubule organizing center, centrosome. Cytoplasm, cytoskeleton, spindle. Cytoplasm, cytoskeleton, spindle pole. Nucleus. Note=Localizes to cytoplasmic microtubules during interphase, to bipolar centrosomes associated with microtubules during prophase, to spindle fibers and spindle poles at metaphase and anaphase, to the midzone during early telophase, and to the midbody in late telophase in cells. Colocalizes with MDM2 in the nucleus.; [Isoform C]: Nucleus. Note=Predominantly nuclear.
-
組織特異性:Isoform A and isoform C are ubiquitously expressed in all tissues tested, however isoform A is absent in many corresponding cancer cell lines. Isoform B is mainly expressed in hematopoietic cells.
-
數據庫鏈接:
Most popular with customers
-
-
YWHAB Recombinant Monoclonal Antibody
Applications: ELISA, WB, IHC, IF, FC
Species Reactivity: Human, Mouse, Rat
-
Phospho-YAP1 (S127) Recombinant Monoclonal Antibody
Applications: ELISA, WB, IHC
Species Reactivity: Human
-
-
-
-
-